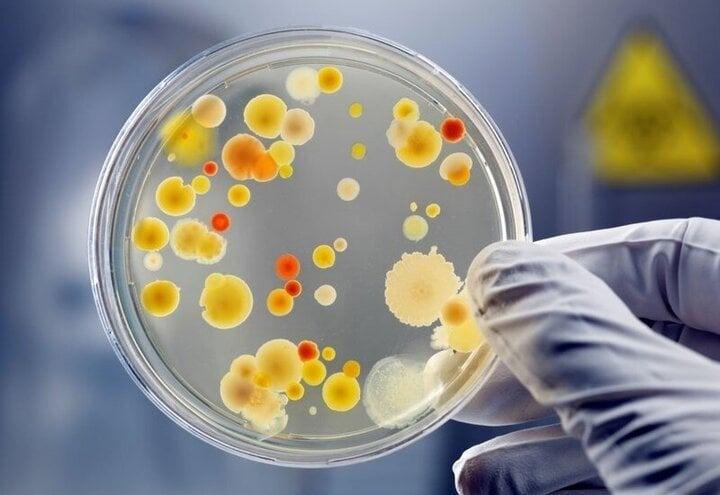
Sang chấn tâm lý khi biết lây bệnh lậu từ bạn gái-1

Biết tin bạn gái quan hệ không an toàn với người khác và bị bệnh lậu, nam thanh niên 25 tuổi ở Hà Nội lo lắng đến mức mất ăn, mất ngủ. Gần đây, anh đau tức vùng kín, tiểu buốt, sau đó đau rát, chảy mủ niệu đạo nên đi khám và phát hiện dịch niệu đạo có vi khuẩn lậu.
Theo bác sĩ Phạm Quang Khải, khoa Phẫu thuật Thận Tiết niệu - Nam học, Bệnh viện E, nam thanh niên đã quan hệ không an toàn dẫn đến lây bệnh lậu từ bạn gái. "Sau khi đọc kết quả, anh bị sang chấn tâm lý", bác sĩ Khải nói.
Bác sĩ kê đơn thuốc kháng sinh liều cao để điều trị bệnh lậu, đồng thời tư vấn người bệnh nên nghỉ ngơi, thư giãn để cải thiện sức khỏe tâm thần.
Theo chuyên gia nam khoa, hiện nhiều bạn trẻ có thái độ cởi mở hơn về việc quan hệ tình dục, nhưng lại không chuẩn bị kiến thức bảo vệ bản thân là nguyên nhân lớn khiến nhiều thanh thiếu niên đối mặt với nguy cơ vô sinh vì mắc bệnh lây qua đường tình dục.
Quan hệ tình dục thiếu lành mạnh như tình một đêm, hay không sử dụng các biện pháp an toàn là nhân tố dẫn đến các bệnh như Chlamydia, lậu cầu nặng hơn có thể gây vô sinh.
Lậu là bệnh do vi khuẩn gram âm neisseria gonorrhoeae gây ra. (Ảnh minh hoạ)
Lậu là bệnh do vi khuẩn gram âm neisseria gonorrhoeae gây ra. Bệnh bùng phát sau 3-6 ngày khi mầm bệnh vào cơ thể. Biểu hiện của bệnh lậu trong thời gian đầu không rõ ràng nên rất khó nhận biết.
Sau vài ngày, người bệnh mới phát hiệu triệu chứng bất thường như vùng kín bị chảy mủ, ngứa hậu môn và chảy máu, một số người bị tiêu chảy và đau khi đi vệ sinh. Khi nhiễm trùng lan sang các khu vực xung quanh như bìu và tinh hoàn, nam giới nguy cơ bị viêm mào tinh hoàn, dẫn đến vô sinh.
Phụ nữ mắc bệnh lậu hầu như không có triệu chứng cụ thể nên thường bị bỏ qua hoặc nhầm lẫn với những bệnh phụ khoa thông thường. Ở giai đoạn nặng, bệnh xuất hiện các triệu chứng như tiểu đau buốt, có mủ màu xanh, vàng chảy ra từ niệu đạo, cổ tử cung, vùng kín có mùi hôi tanh bất thường.
Biến chứng khác của bệnh lậu là làm tăng nguy cơ lan rộng hoặc bị nhiễm HIV. Các vi khuẩn lan vào máu và các bộ phận khác cơ thể như đến các khớp gây sưng đau, vào mắt gây ảnh hưởng thị lực. Phụ nữ mang thai nhiễm lậu có thể truyền bệnh sang con, ảnh hưởng rất lớn đến sự phát triển thể chất và trí tuệ của trẻ.
Theo bác sĩ, nếu bệnh nhân thấy đau buốt, chảy dịch, chảy mủ niệu đạo sau quan hệ tình dục không an toàn như thay đổi bạn tình, không mang bao cao su, bao cao su bị rách, cần khám và điều trị sớm.
Phát hiện sớm, bệnh nhân có thể dùng thuốc kháng sinh đặc trị chống lại vi khuẩn lậu. Điều trị đúng thuốc, đủ liều thì triệu chứng tiểu rắt, tiểu buốt, tiểu nhiều lần sẽ giảm nhanh sau 24-48 giờ, riêng tiểu ra mủ sẽ hết chậm hơn sau 48-72 giờ. Các triệu chứng chung có thể biến mất hoàn toàn sau 5-7 ngày.
Khi bệnh tiến triển nặng cần điều trị bằng phương pháp ngoại khoa nhằm phá hủy triệt để mầm bệnh, ngăn ngừa tái phát.
Bác sĩ khuyến cáo người bệnh tuyệt đối không tự ý dùng thuốc tránh tình trạng kháng thuốc. Nam giới khi thấy dương vật bị sưng, tiểu buốt hoặc chị em thấy ra khí hư bất thường thì nên đi khám bác sĩ chuyên khoa.
Theo VTCnews
